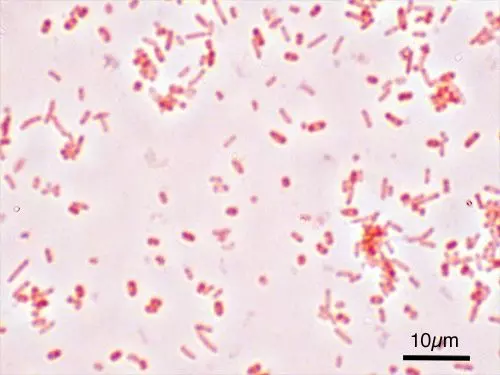
Salmonella Typhi Gram Stain SimpleMed

Next Lesson - Gastrointestinal Emergencies
Abstract
- The gastrointestinal tract is a microbiome.
- The stomach is a microaerophilic environment, the proximal gut is a relatively sterile environment, and the colon is an anaerobic environment containing 1011 bacteria.
- The microbiome has many advantages such as making harmful bacteria compete for nutrients; producing short-chain fatty acids that aid cholesterol metabolism, help regulate satiety and provide energy to colonocytes; and producing nutrients such as vitamin K.
- Gastroenteritis is the term used to describe inflammation of the stomach and intestines due to infection and typically presents with diarrhoea and/or vomiting.
- Enterocolitis is very similar but describes the inflammation of the distal GI tract so does not affect the stomach and therefore is less likely to present with vomiting.
Core
The gastrointestinal tract is a microbiome. The stomach is a microaerophilic environment, the proximal gut is a relatively sterile environment, and the colon is an anaerobic environment containing approximately 1011 bacteria per gram of contents. The microbiome has many advantages such as making harmful bacteria compete for nutrients; producing short-chain fatty acids that aid cholesterol metabolism, help regulate satiety and provide energy to colonocytes; and producing nutrients such as vitamin K.
Gastroenteritis and enterocolitis are terms used to describe inflammation (-itis) in the stomach (gastro-), intestines (entero-) or colon (col-). It is usually caused by an infection, but there are non-infectious causes such as food sensitivity, medications or stress. These non-infectious causes present very similarly to infectious gastroenteritis or enterocolitis, but have no causative organism.
Generally, gastroenteritis or enterocolitis will present with some combination of nausea, vomiting, diarrhoea, abdominal pain and fever. Not all organisms cause all of these symptoms, but this is the common picture, and inflammation of the distal gastrointestinal (GI) tract (enterocolitis) is less likely to present with vomiting as the inflammation does not include the stomach.
Below are the common organisms that cause gastroenteritis and enterocolitis.

Image - Bacteria in the gastrointestinal tract
Public Domain Source [Public domain]
Gram-positive bacillus.
Spreads via faeco-oral route.
Incubation period of around 48 hours.
Salmonella typhi enter enterocytes via endocytosis and then travel to the submucosa of the intestines. Here they encounter macrophages which transfer them to the reticuloendothelial system where they multiply. They then cause lymphoid hyperplasia and re-enter the gut to continue the cycle.
Presents with fever, abdominal pain, and non-bloody diarrhoea.
In healthy individuals, Salmonella infections are self-limiting within 4-7 days and do not require treatment with antibiotics. Supportive treatment with fluid and electrolyte replacement may be required. In patients with compromised immune systems, antibiotics may be needed, but this is rare.
Image - Gram stain of Salmonella typhi
Creative commons source by Y tambe [CC BY-SA 4.0 (https://creativecommons.org/licenses/by-sa/4.0)]
Gram-negative bacillus (‘S’ shaped).
Spreads via faeco-oral route.
Incubation period of up to 7 days.
Campylobacter jejuni penetrates the intestinal mucus layer, releases cytotoxins and causes disruption to the epithelial lining of the intestines.
Presents with fever, abdominal pain, and diarrhoea (often bloody).
In healthy individuals, Campylobacter infections are self-limiting within 7-10 days. Supportive treatment with fluid and electrolyte replacement may be required, and in severe cases, antibiotics can be used.
Complications can include Guillain-Barre syndrome.

Image - Gram stain of Campylobacter jejuni
Public Domain Source [Public domain]
Gram-negative bacillus.
Spreads via faeco-oral route.
Incubation period of around 48 hours.
Highly virulent.
Shigella bacteria invade colonocytes, multiply and then invade neighbouring cells - killing them and forming abscesses in the intestinal wall.
Presents with bloody diarrhoea (often containing mucus) and abdominal cramps.
In healthy individuals, Shigellosis (infection with the shigella bacteria) is self-limiting within 7 days. Supportive treatment with fluid and electrolyte replacement may be required and in severe cases, antibiotics can be used.

Image - Gram stain of Shigella flexneri
Creative commons source by B. Domangue [CC BY-SA 4.0 (https://creativecommons.org/licenses/by-sa/4.0)]
Gram-negative bacillus.
Spreads via faeco-oral route.
Incubation period of 24-72 hours.
Most common cause of ‘Traveller’s diarrhoea’.
E. coli invades enterocytes and produces enterotoxins that cause hypersecretion of chloride ions into the gut lumen - water follows the osmotic gradient into the lumen, leading to diarrhoea.
Presents with fever, abdominal pain, and non-bloody diarrhoea.
In healthy individuals, E. coli infections are self-limiting within 4-7 days and do not require treatment with antibiotics. Supportive treatment with fluid and electrolyte replacement may be required.

Image - Gram stain of Escherichia coli
Creative commons source by Dr Graham Beards [CC BY-SA 4.0 (https://creativecommons.org/licenses/by-sa/4.0)]
Gram-negative bacillus.
Anaerobic and spore-forming. Spores are very difficult to remove from an environment.
Spreads via faeco-oral route.
C. difficile infections occur following antibiotic therapy. This is because C. difficile is part of the normal gut bacteria, and competes for survival in this environment. When the antibiotics wipe out the rest of the normal gut flora, C. difficile colonises the gut in the normal flora’s absence and releases enterotoxins/cytotoxins.
Presents with diarrhoea and abdominal cramping.
Treatment involves the removal of the causative antibiotic, fluid/electrolyte replacement and oral vancomycin or fidaxomicin. Antibiotics used to treat C. difficile are given orally so they reach the gut.
Complications include toxic megacolon and amoebic liver abscess.

Image - Gram stain of Clostridium difficile
Public Domain Source by Don Stalons [Public domain]
Double-stranded RNA virus.
Very common cause of gastroenteritis in children under 5 years old, but much less common in adults.
Presents with fever, vomiting and diarrhoea.
In healthy individuals, rotavirus infections are self-limiting within 3-5 days. Supportive treatment with fluid and electrolyte replacement may be required.

Image - Computer reconstructed image of a rotavirus particle that has reacted with monoclonal antibodies
Creative commons source by GrahamColm, edited by Dr. Laura Hansell [CC BY-SA 4.0 (https://creativecommons.org/licenses/by-sa/4.0)]
RNA virus.
Incubation period of 24-48 hours.
Most common cause of non-bacterial gastroenteritis. It can occur in adults or in children.
Causes brush border enzyme disruption.
The large number of strains and the small dose required to produce symptoms result in norovirus being highly contagious.
Presents with fever, vomiting and watery diarrhoea.
In healthy individuals, norovirus infections are self-limiting within 3 days. Supportive treatment with fluid and electrolyte replacement may be required.

Image - A single norovirus virion
Public Domain Source by CDC [Public domain]
Sporozoan protozoa.
Spreads via faeco-oral route or via water.
The disease cycle involves ingestion of oocyst containing the parasite, reproduction within the epithelial cells of the small intestine and excretion of the oocyst in the faeces to continue the cycle.
Causes brush border enzyme dysfunction and increased chloride ion secretion.
Presents with watery diarrhoea.
In healthy individuals, Cryptosporidium infections are self-limiting within 2 weeks. Supportive treatment with fluid and electrolyte replacement may be required.
In at-risk groups (e.g. patients with HIV or other immunocompromised states) anti-parasitic treatments may be used.
Flagellate protozoa.
Spreads via faeco-oral route or via water.
Incubation period of 1-2 weeks.
More common in children than adults.
The disease cycle involves ingestion of a cyst containing the parasite. Stomach acid and pancreatic enzymes release the parasite to multiply in the small intestine over 1-2 weeks. The parasite causes villous atrophy in the small intestine and is then excreted in the faeces to continue the cycle.
Presents with diarrhoea.
Treatment involves antimicrobials such as metronidazole and supportive treatment with fluid and electrolyte replacement may be required.
Amoeba protozoa.
Spreads via faeco-oral route or via water.
Increasing prevalence in developing countries.
The disease cycle involves ingestion of a cyst containing the parasite. Then excystation occurs in the colon where trophozoites invade the mucosa and cause inflammation (they may then spread to the liver). Cysts are then excreted in the faeces to continue the cycle.
Most often asymptomatic but may present with bloody diarrhoea. In rare cases, it may present with symptoms of a liver abscess such as fever and right upper quadrant pain.
Treatment involves antimicrobials such as metronidazole and supportive treatment with fluid and electrolyte replacement may be required.
Complications include pseudomembranous colitis and toxic megacolon.
Edited by: Dr. Maddie Swannack
Reviewed by: Dr. Thomas Burnell
- 510

